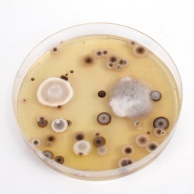
Allergie gegen Schimmelpilze

- Alle Themen
- Allergie
- Atemwege
- Augen & Sehen
- Blut, Lymphen, Drüsen
- Erkältung & Grippe
- Ernährung & Fitness
- Geschlechtskrankheiten
- Hals, Nase, Ohren
- Haut & Haare
- Herz & Kreislauf
- Infektionen & Viren
- Krebs
- Magen & Darm
- Medikamente
- Muskeln & Knochen
- Naturheilkunde
- Nieren & Harnwege
- Psyche & Nerven
- Reise
- Rücken
- Schmerzen
- Schwangerschaft
- Schönheit & Ästhetik
- Senioren
- Sexualität & Partnerschaft
- Stoffwechsel
- Zähne & Mund
- Thema
- Alle Themen
- Allergie
- Atemwege
- Augen & Sehen
- Blut, Lymphen, Drüsen
- Erkältung & Grippe
- Ernährung & Fitness
- Geschlechtskrankheiten
- Hals, Nase, Ohren
- Haut & Haare
- Herz & Kreislauf
- Infektionen & Viren
- Krebs
- Magen & Darm
- Medikamente
- Muskeln & Knochen
- Naturheilkunde
- Nieren & Harnwege
- Psyche & Nerven
- Reise
- Rücken
- Schmerzen
- Schwangerschaft
- Schönheit & Ästhetik
- Senioren
- Sexualität & Partnerschaft
- Stoffwechsel
- Zähne & Mund
- Kategorie
Allergie

Akupunktur
Die Akupunktur ist ein Teilgebiet der traditionellen chinesischen Medizin (TCM) und wird in der Regel als Regulationstherapie angewendet. Andererseits kann mit der Akupunktur aber auch einfach nur symptomatisch behandelt werden. Sie kann bei akuten und ...

Akupunktur - Anwendung und Wirksamkeit
Grundlegendes über die Wirkungsprinzipien der Akupunktur Yin und Yang als polare Kräfte des Universums sind in der Akupunktur von besonderer Bedeutung. Ein Zuviel an männlicher und positiver Yang-Energie gilt als Überfunktion, ein Zuwenig als Unterfunktion. ...

Allergie (Überempfindlichkeitsreaktion)
Eine Allergie ist eine Abwehrreaktion des Immunsystems auf eigentlich harmlose körperfremde Umweltstoffe, sogenannte Allergene. Es handelt sich dabei um eine Überreaktion des Körpers, die Fremdstoffe werden wie gefährliche Krankheitserreger behandelt. Die ...

Allergie bei Baby und Kind
Immer mehr Menschen reagieren mit Allergien. Eine ist eine Überempfindlichkeitsreaktion auf bestimmte Fremdstoffe (Allergene) aus der Umwelt, die üblicherweise harmlos sind. Dies können Nahrungsmittel, Hausstaub, Tierhaare oder Pollen sein. Das menschliche ...

Allergie bei Hausstaubmilben
Hausstaubmilben sind kleine Spinnentiere, die mit bloßem Auge nicht erkennbar sind. Sie leben im Hausstaub und ernähren sich von abgestorbenen Hautschuppen. Da der Mensch jeden Tag zwischen 1 Gramm und 15 Gramm Schuppen verliert, sind unsere Wohnungen für sie ...

Allergie gegen Insektengift
Viele haben Angst davor, von Insekten gestochen zu werden. Der Stich einer Biene, Wespe, Hummel oder Hornisse kann sehr schmerzhaft sein und brennen, das dabei abgegebene Gift führt zu Schwellungen und starkem Juckreiz – im Normalfall ist das aber harmlos. ...
Allergie gegen Schimmelpilze
Sie lieben es warm und feucht und bleiben lange unentdeckt. Schimmelpilze fühlen sich in Innenräumen äußerst wohl und breiten sich besonders gerne in Bade- und Schlafzimmern, in Kellerräumen, an Fensterstürzen, in Raumecken und an Schrankrückseiten aus. Auch ...

Allergie gegen Tierhaare
Zu Tränen gerührt wegen des süßen Kätzchens? Der Hund verschlägt Ihnen den Atem? – So liebenswert die Vierbeiner als Haustiere sind, wenn Sie mit solchen Symptomen reagieren, dann herrscht Allergiealarm. Jeder dritte Tierhalter leidet unter einer ...

Allergietest (Pricktest)
Mit dem Prick-Test (engl. prick = Einstich) kann schnell und relativ sicher eine Überempfindlichkeit auf allergene Stoffe bestimmt werden. Dazu werden sehr geringe Mengen verschiedener Allergene über die Haut in den Organismus gebracht. Entstehungszeit und ...

Allergische Haut
"Das juckt mich nicht!" Schön, wer das sagen kann. Oft gehen einem aber Dinge „unter die Haut“, man ist „dünnhäutig“, empfindlich. Diese Redewendungen beziehen sich zwar meistens auf unangenehme Ereignisse im Leben, doch sie sagen indirekt auch viel über die ...
News zum Thema Allergie
Heuschnupfen – Was hilft wirklich?
Ratschläge zur Bekämpfung des alljährlichen Heuschnupfens gibt es reichlich – doch was hilft wirklich? Bei einer Allergie oder bei Heuschnupfen reagiert das Immunsystem zu stark auf die Erreger ...
weiterlesenFisch schützt Kinder vor Allergie und Asthma
Häufiger Fisch zu essen, könnte Kinder vor Allergien und Asthma bewahren, ergab eine schwedische Studie. Die positive Wirkung auf das Immunsystem ist den im Fisch enthaltenen, mehrfach ungesättigten Fettsäuren ...
weiterlesenWurmprotein könnte Asthma heilen
Fadenwürmer könnten für Asthmapatienten heilsam sein. Ein Protein der Würmer könnte vor allergischen Reaktionen schützen. Die meisten Asthmapatienten leiden unter Allergien ...
weiterlesenHaustiere können vor Asthma schützen
Haustiere, aber auch Ungeziefer und andere Allergene können Kinder vor Asthma schützen. Allerdings sollten die Kinder mit den Allergenen bereits im Alter von unter drei Jahren Kontakt haben ...
weiterlesenSchwangerschaft: Zucker fördert Asthma
Zu viel Zucker ist nicht nur aufgrund der vielen Kalorien ungesund. Der Zuckerkonsum in der Schwangerschaft steht auch mit Asthmaerkrankungen des Nachwuchses in Zusammenhang ...
weiterlesenWas schlechter Innenluft vorbeugt
Auch zu Hause in den Innenräumen kann die Luft schlecht sein. Hauptverursacher sind Zigarettenrauch, Kerzen, Reinigungsmittel sowie das Braten von Nahrungsmitteln. Die Luftverschmutzung zuhause kann ...
weiterlesenPollenallergie setzt Schülern zu
Im Frühjahr ist für Schüler oftmals Prüfungszeit. Bei bestehender Pollenallergie ist die Leistung aber eingeschränkt, so Forscher. Das Immunsystem von Pollenallergikern arbeitet auf Hochtouren ...
weiterlesenGelenkersatz: Frauen reagieren auf Metall
Nach einem Gelenkersatz kommt es bei Frauen häufiger zu Komplikationen als bei Männern. Eine Ursache könnte das Metall in Gelenkimplantaten sein, finden Forscher heraus. Frauen neigen eher ...
weiterlesenHaustiere gegen Allergien und Übergewicht
Haben Kinder schon früh im Leben zu Haustieren Kontakt, kommt das ihrer Gesundheit zugute. Sie entwickeln weniger wahrscheinlich Allergien und auch Übergewicht kommt bei ihnen ...
weiterlesenNussallergien zu häufig diagnostiziert?
Menschen, die unter einer Baumnussallergie leiden, wird häufig empfohlen, auch andere Nüsse zu meiden. Experten meinen, das sei oft unnötig. Wer auf eine Arten von Nüssen allergisch reagiert, verträgt ...
weiterlesen